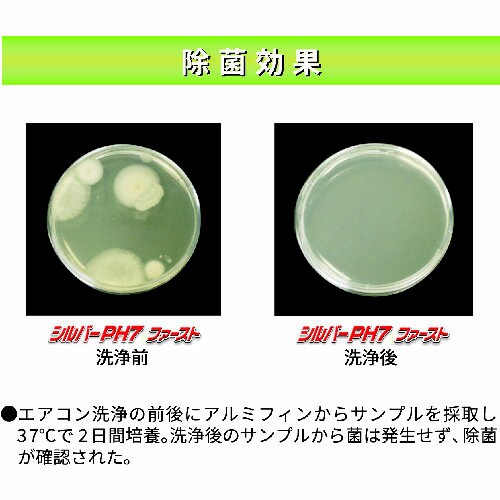
シルバーPH7ファースト 10kg

第7位
横浜油脂工業
シルバーPH7ファースト 10kg 4915 洗浄剤 1個
【7032-6567】



| ¥8,800 (税込) / ¥8,000 (税抜) |
| ¥8,800 (税込) / ¥8,000 (税抜) |
| メーカー希望小売価格 オープン |
|---|
洗浄剤の売れ筋ランキング
- ¥590(税込) (税込)
- ¥475(税込) (税込)
- ¥723(税込) (税込)
- ¥3,465(税込) (税込)
- ¥634(税込) (税込)
- ¥933(税込) (税込)
- ¥8,800(税込) (税込)
商品の特徴 |
アルミフィンを傷めず洗浄後の中和処理が不要です。生分解性の高い界面活性剤を配合しています。 |
|---|---|
商品仕様 |
|
メーカー情報 |
|
カタログ掲載ページ |
-/- |
| 注意事項 | ※【返品に関するご注意】この商品は直送品のため、お客様のご都合による返品はお受けできません。 |
|---|